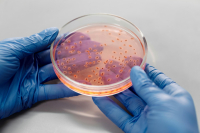
Χρυσίζων σταφυλόκοκκος: Πόσο επικίνδυνο είναι το μικρόβιο - Τα συμπτώματα

Ανακαλείται παρτίδα γνωστού αποσυμφορητικού μύτης στις ΗΠΑ καθώς μετά από σχετικούς ελέγχους εντοπίστηκε περιστατικό μικροβιακής μόλυνσης του προϊόντος από σταφυλόκοκκο.
Ειδικότερα, η Ascent Consumer Products Inc. ανακαλεί εθελοντικά μία παρτίδα του Συστήματος Ρινικής Πλύσης με Μαλακή Άκρη και Μπουκάλι Σφήνας SinuCleanse. Η χρήση του Συστήματος Ρινικής Πλύσης με Μαλακή Άκρη και Μπουκάλι Σφήνας SinuCleanse, το οποίο έχει μολυνθεί με S. aureus, μπορεί να προκαλέσει λοιμώξεις του αίματος σε χρήστες των οποίων η ρινική βλεννογόνος μπορεί να έχει καταστραφεί λόγω φλεγμονής και μηχανικών τραυμάτων που προκαλούνται από την ρινική πλύση. Οι δευτερογενείς λοιμώξεις που μπορεί να προκύψουν περιλαμβάνουν ενδοκαρδίτιδα (λοίμωξη του εσωτερικού τοιχώματος της καρδιάς), λοιμώξεις οστών και αρθρώσεων, απόστημα στη σπλήνα ή μηνιγγίτιδα, καθώς και βακτηριακή ιγμορίτιδα, η οποία μπορεί να οδηγήσει σε λοιμώξεις των ιστών των ματιών, προβλήματα όρασης, βλάβη των κρανιακών νεύρων ή μηνιγγίτιδα. Αυτές οι λοιμώξεις είναι σοβαρές και δυνητικά απειλητικές για τη ζωή. Μέχρι σήμερα, δεν έχουν αναφερθεί αρνητικά περιστατικά στην Ascent Consumer Products, Inc. που να σχετίζονται με αυτή την ανάκληση.
Το Συστήμα Ρινικής Πλύσης με Μαλακή Άκρη και Μπουκάλι Σφήνας SinuCleanse χρησιμοποιείται για την πλύση των ρινικών διόδων για την προσωρινή ανακούφιση των συμπτωμάτων που σχετίζονται με τη ιγμορίτιδα, το κρυολόγημα, τη γρίπη ή τις αλλεργίες.
Αυτή είναι η παρτίδα που ανακαλείται
Συστήμα Ρινικής Πλύσης με Μαλακή Άκρη και Μπουκάλι Σφήνας SinuCleanse | 024122661A1 | 31-12-2027
Το Συστήμα Ρινικής Πλύσης με Μαλακή Άκρη και Μπουκάλι Σφήνας SinuCleanse συσκευάζεται σε κουτί, το οποίο περιέχει το μπουκάλι σφήνας και 30 φακελάκια φυσιολογικού ορού. Ο αριθμός παρτίδας και η ημερομηνία λήξης μπορούν να εντοπιστούν στο πλάι του κουτιού ή στην πίσω πλευρά των φακελίσκων φυσιολογικού ορού εντός του κουτιού. Η επηρεασμένη παρτίδα διανεμήθηκε τον Ιανουάριο του 2025 σε όλη τη χώρα μέσω καταστημάτων λιανικής και διαδικτυακών καταστημάτων.
Η Ascent Consumer Products Inc. ενημερώνει τους διανομείς και τους πελάτες της μέσω ηλεκτρονικού ταχυδρομείου. Οι διανομείς και οι έμποροι που κατέχουν την επηρεασμένη παρτίδα θα πρέπει άμεσα να σταματήσουν τη διανομή και να αφαιρέσουν το ανακληθέν προϊόν από το απόθεμά τους. Οι καταναλωτές που διαθέτουν αυτό το προϊόν πρέπει να σταματήσουν τη χρήση του άμεσα και να το επιστρέψουν στο σημείο αγοράς ή να το απορρίψουν.